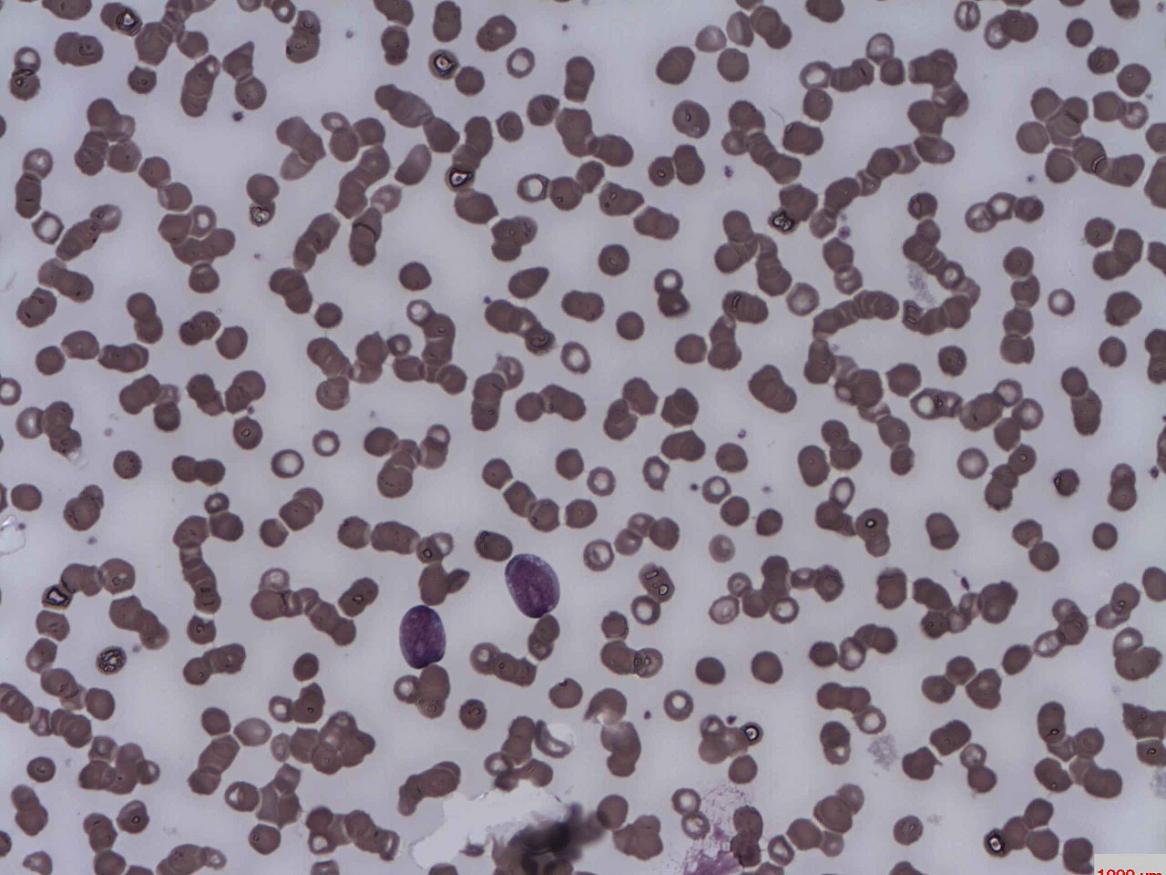
Acute lymphoblastic Leukaemia

Honours in Molecular and Biomedical Science
Study honours in molecular and biomedical science become immersed in critical research into the molecular basis of human disease, animal and plant evolution.
When you choose honours in molecular and biomedical science, you become a member of the School of Biological Sciences and part of a research group.
You'll work alongside scientists at the cutting-edge of their field and complete a research project in the general discipline areas of biochemistry, genetics, microbiology, or immunology. There's also related theoretical work appropriate to these disciplines.

Honours handbook
The molecular and biomedical science honours handbook contains an overview of the program and activities, example timetable and a summary of the assessment process.
Honours projects
Supervisors with available molecular and biomedical science projects have been added to the 'honours project finder'. If you are interested in their research you should talk with the respective supervisors to discuss potential projects.
If you are interested in a particular area of research that's not included, talk with our honours coordinator Professor Robert Richards to discuss other opportunities to develop an honours project.
Project search by theme or supervisor.
-
Supervisors - Department of Molecular and Biomedical Science
These primary supervisors are based in the Department of Molecular and Biomedical Science in the School of Biological Sciences.
Supervisor Area Prof David Adelson Bioinformatics and computational genetics Dr Mohammed Alsharifi Vaccine research A / Prof Michael Beard Viral pathogenesis Dr John Bruning Laboratory of Protein Crystallography Dr Jack Da Silva Evolutionary genetics of sex, sexes and senescence (s3) Dr Ian Dodd Synthetic biology, biochemistry, genetics and mathematical modelling Prof Antonio Ferrante Development and genetic immunology, immunopathology Dr Sonja Frolich Malaria parasites Prof Frank Grutzner Monotreme genomics, evolution and conservation Dr Nan Hao Synthetic biology, biochemistry, genetics and mathematical modelling Dr Stephen Kidd Pathogenic bacteria A / Prof Michael Lardelli Alzheimer's Disease Genetics Laboratory Dr Morgan Newman Alzheimer's Disease Genetics Laboratory Dr Louise O'Keefe Genetics A / Prof Dan Peet Biochemistry and molecular biology Tahlia Perry Monotreme genomics, evolution and conservation Prof Robert Richards Genetics Dr Iain Searle Epigenetics and plant reproductive biology A / Prof Keith Shearwin Synthetic biology, biochemistry, genetics and mathematical modelling Dr Linda Shearwin Genetics, monotreme genomics, evolution and conservation Dr Elizabeth Tran Shigella flexneri Dr Danny Wilson Malaria parasites -
Affiliate supervisors - Department of Molecular and Biomedical Science
The following is a list of affiliated scientists who offer honours projects through the Department of Molecular and Biomedical Science.
- Adikusuma, Dr Fatwa
- Apaja, A/Prof Pirjo
- Bandara, Dr Veronika
- Barry, Prof Simon
- Brown, Dr Cheryl
- Byers, Dr Sharon
- Care, Dr Alison
- Corbett, Dr Mark
- Derrick-Roberts, Dr Ainslie
- Eadie, Dr Laura
- Ferrante, Prof Antonio
- Fuller, A/Prof Maria
- Gecz, Prof Jozef
- Heatley, Dr Susan (Sue)
- Hemsley, A/Prof Kim
- Jolly, Dr Lachlan
- McClure, Dr Barbara
- McIntyre, Dr Chantelle
- Moldenahuer, Dr Lachlan
- O'Keefe, Dr Louise
- Pham, Dr Duyen
- Proud, Prof Chris
- Robertson, Prof Sarah
- Sadlon, Dr Tim
- Schjenken, Dr John
- Sharma, Dr Raman
- Shearwin, Dr Linda
- Shoubridge, A/Prof Cheryl
- Tasheva, Dr Stefka
- Thomas, Prof Paul
- Van der Hoek, Dr Kylie
- van Eyk, Dr Clare
- White, Prof Deborah
-
Biochemistry projects
Gene therapy to treat inherited brain disease
Honours project: Be involved in clinical trials for inherited disorders that affect the brain.
Read more about Gene therapy to treat inherited brain diseaseBone abnormalities in genetic disease
Honours project: Learn about bone dynamics in inherited metabolic disorders with the ultimate aim of uncovering new opportunities for therapeutic intervention.
Read more about Bone abnormalities in genetic diseaseActivity of novel xylanases from a new Australian crop, Plantago ovata (psyllium)
Honours project: Study the biology of psyllium, a plant whose seeds are used as a key ingredient in the gluten-free food industry.
Read more about Activity of novel xylanases from a new Australian crop, Plantago ovata (psyllium)Where does the acid in wine come from?
Honours project: Can you help find the missing link in grape berry biochemistry?
Read more about Where does the acid in wine come from?Does eating cruciferous vegetables protect us against breast cancer?
Honours project: Explore the anti-breast cancer actions of isothiocyanates from cruciferous vegetables.
Read more about Does eating cruciferous vegetables protect us against breast cancer?Determining the effect of protein quality control to astrocyte stress responses
Honours project: Learn how brain cells are adapting to different stress responses, and what happens to this adaptation if the protein quality control is compromised.
Read more about Determining the effect of protein quality control to astrocyte stress responsesUbiquitin signalling in human diseases
Honours project: Investigate the effect of ubiquitin signalling on cell differentiation.
Read more about Ubiquitin signalling in human diseasesHow do cancer cells become aggressive?
Honours project: Investigate the function of alternative splice variants in cancer cell plasticity.
Read more about How do cancer cells become aggressive?How microRNAs regulate breast cancer metastasis
Honours project: Determine the target genes of microRNAs that function in breast cancer progression and metastasis using cell culture models.
Read more about How microRNAs regulate breast cancer metastasisSnake venom proteins
Honours project: Gain new insights into higher order protein structures in selected snake venoms.
Read more about Snake venom proteinsStructural study of misfolding proteins
Honours project: Investigate the structural characterisation of protein misfolding in amyloid diseases, such as Alzheimer’s and Parkinson’s.
Read more about Structural study of misfolding proteinsSaving megafauna from bacteria
Honours projects: Identify and image biofilms that threaten the Naracoorte Caves National Park fossils.
Read more about Saving megafauna from bacteriaMaking a bistable switch
Honours project: This honours project involves the design, construction and testing of an activator based bistable switch.
Read more about Making a bistable switchRole of HIFs in cancer
Honours project: Decipher the specific roles of HIF1 and HIF2 in multiple myeloma.
Read more about Role of HIFs in cancerSynthetic phage therapy
Honours project: Investigate the structural biology of bacteriophage proteins.
Read more about Synthetic phage therapyDeciphering & exploiting bacterial cholesterol metabolism to combat disease
Honours project: Address the fundamental science behind the use of the steroid cholesterol as a source of energy by bacteria.
Read more about Deciphering & exploiting bacterial cholesterol metabolism to combat diseaseRole of eEF2K & cancer cell migration & invasion
Honours project: Study cell signalling and gene regulation through the exploration of the role of eukaryotic elongation factor 2 kinase (eEF2K) and cancer cell migration and invasion.
Read more about Role of eEF2K & cancer cell migration & invasionSystematic analysis of the eIF4E interactome
Honours project: Conduct a systematic analysis of the eIF4E interactome to understand the distinct functional roles of the three mammalian eIF4E proteins in translation initiation.
Read more about Systematic analysis of the eIF4E interactomeExploring the functions of MAPK-interacting kinases (MNKs) in metabolic disease
Honours project: Explore the functions of MAPK-interacting kinases (MNKs) in metabolic disease at the South Australian Health and Medical Research Institute.
Read more about Exploring the functions of MAPK-interacting kinases (MNKs) in metabolic diseaseBlinatumomab in relapsed acute lymphoblastic leukaemia
Honours project: Investigate resistance mechanisms to the bispecific T-cell engager (BiTE) blinatumomab in relapsed acute lymphoblastic leukaemia.
Read more about Blinatumomab in relapsed acute lymphoblastic leukaemiaCloning acute lymphoblastic leukaemia fusion genes and variants
Honours project: Clone full-length fusion-genes and gene variants from patient material into mammalian expression plasmids.
Read more about Cloning acute lymphoblastic leukaemia fusion genes and variants
more...01
Jan
Retinal energy metabolism and links to eye disease
Honours project: Investigate retinal metabolism associated with eye disease.
01
Jan
Directed evolution of proteins in vivo
Honours project: Use a new phage-based directed evolution approach to evolve proteins with properties to make them suitable for use in synthetic circuit applications, such as in vivo biosensing or construction of bistable switches.
01
Jan
Honours project: This genome editing project focuses on developing CRISPR gene therapy for Duchenne Muscular Dystrophy (DMD).
01
Jan
Honours project: Develop a stronger understanding of the pathological mechanism of PCDH19-girls clustering epilepsy.
01
Jan
Development of CRISPR gene drive technology in mice
Honours project: Explore CRISPR gene drives to modify native or invasive pest populations to benefit human health, ecosystems or agriculture.
-
Genetics projects
Bone abnormalities in genetic disease
Honours project: Learn about bone dynamics in inherited metabolic disorders with the ultimate aim of uncovering new opportunities for therapeutic intervention.
Read more about Bone abnormalities in genetic diseaseGene therapy to treat inherited brain disease
Honours project: Be involved in clinical trials for inherited disorders that affect the brain.
Read more about Gene therapy to treat inherited brain diseaseCRISPR genome editing approach for vetch improvement
Honours project: Opportunities to use state-of-the-art next generation breeding technology to improve vetch seed nutrition.
Read more about CRISPR genome editing approach for vetch improvementUnderstanding pollination processes between bees and flowers
Honours project: Investigate the molecular basis of extrorse anther outcrossing mechanism in flowering plants.
Read more about Understanding pollination processes between bees and flowersDisease resistance in plants: Chickpea
Honours project: Combine your passion for agriculture, plant science and bioinformatics to investigate genetic resistance to disease in chickpea.
Read more about ChickpeaDisease resistance in plants: Oat
Honours project: Combine your passion for agriculture, plant science and bioinformatics to investigate the genetics of septoria leaf blotch to aid the development of resistant oat varieties.
Read more about OatRole of an RNA m5C methyltransferase during plant reproduction
Honours project: Investigate the role of an RNA m5C methyltransferase during early reproductive development as mutants abort early during seed development.
Read more about Role of an RNA m5C methyltransferase during plant reproductionMolecular biology analysis of the function of Alzheimer's disease genes
Honours project: Investigate the molecular biology of the function of Alzheimer's disease genes.
Read more about Molecular biology analysis of the function of Alzheimer's disease genesBehavioural analysis of zebrafish models of Alzheimer's Disease
Honours project: Undertake behavioural analysis of zebrafish models in order to help find treatments for Alzheimer's Disease.
Read more about Behavioural analysis of zebrafish models of Alzheimer's DiseaseCellular-stress induced activation of non-TFEB regulated lysosomal genes
Honours project: Investigate the role of the eIF2α/ATF4 pathway in stress-induced transcription of non-TFEB genes.
Read more about Cellular-stress induced activation of non-TFEB regulated lysosomal genesEchidna biology for conservation, wildlife management & habitat monitoring
Honours project: This project investigates the molecular basis of echidna biology for application in conservation, wildlife management and habitat monitoring.
Read more about Echidna biology for conservation, wildlife management & habitat monitoringBioinformatics as applied to the study of genome structure and function
Honours project: Expand your knowledge and curiosity in bioinformatics and computational genetics.
Read more about Bioinformatics as applied to the study of genome structure and functionOptimisation of chimeric antigen receptor immunotherapy: building a better car?
Honours project: Undertake an honours project in the construction and evaluation of a novel Chimeric Antigen Receptor T cell targeting a solid tumour antigen.
Read more about building a better car?Genome biology & mammal gene evolution
Honours project: Examine the function and evolution of genes involved in sex determination and placentation in mammals.
Read more about Genome biology & mammal gene evolutionInvestigating the origin of mammal sex chromosomes
Honours project: Undertake a research project that investigates the origin of therian sex chromosomes
Read more about Investigating the origin of mammal sex chromosomesHill-Robertson interference, the Red Queen and the evolution of sex
Honours project: This evolutionary genetics honours project explores the Hill-Robertson interference, the Red Queen and the evolution of sex.
Read more about Hill-Robertson interference, the Red Queen and the evolution of sexTesting the gamete competition theory of the evolution of anisogamy
Honours project: Explore genetics and evolutionary biology by testing the gamete competition theory of the evolution of anisogamy.
Read more about Testing the gamete competition theory of the evolution of anisogamyEchidna CSI: a citizen science platform for outreach, engagement, communication and education
Honours project: Join the Echidna Conservation Science Initiative (EchidnaCSI) and complete an honours project in science communication or education.
Read more about a citizen science platform for outreach, engagement, communication and educationEvolution of sterile helpers in bees, ants and wasps
Honours project: Explore evolutionary genetics by explaining the evolution of sterile helpers in the eusocial Hymenoptera - ants, bees and wasps.
Read more about Evolution of sterile helpers in bees, ants and waspsEchidna CSI [Conservation Science Initiative]
Honours project: Get involved the citizen science project that combines field ecology and molecular biology for echidna conservation.
Read more about Echidna CSI [Conservation Science Initiative]The echidna genome project
Honours project: Take part in an international collaboration that will provide the first echidna genome assembly.
Read more about The echidna genome projectPlasticity of lifespan in the honeybee & the disposable soma theory
Honours project: This project investigates the plasticity of lifespan in the honeybee and the disposable soma theory.
Read more about Plasticity of lifespan in the honeybee & the disposable soma theorySex chromosomes of the platypus & echidna
Honours project: Study the meiotic organisation of monotreme sex chromosomes – that’s genetics research into the platypus and echidna.
Read more about Sex chromosomes of the platypus & echidna
more...01
Jan
Understanding the molecular mechanisms of intellectual disability
Honours project: Investigate the role IQSEC2 and synaptic morphology and plasticity on the orchestration of the complex architecture required for ‘normal’ cognition.
01
Jan
Investigating molecular mechanisms of disease
Honours project: Characterise molecular and cellular changes driving improvements to disease outcomes after postnatal 17B-estradiol treatment in mice modelling intellectual disability and seizures.
01
Jan
Do MPS patient derived stem cells form bone and cartilage?
Honours project: This project in genetics and molecular pathology examines the characterisation of patient derived stem cells.
01
Jan
Honours project: Help understand the biology of human brain function by studying major neurological disorders which are genetically determined.
01
Jan
WWOX Enzyme function is a target for treatment of metabolic diseases including cancer
Honours project: This genetics research project will explore the WWOX Enzyme function as a target for the treatment of metabolic diseases including cancer.
01
Jan
‘Non-self’ & organelle quality control mutations
Honours project: Explore a project in ‘Non-self’ and organelle quality control mutations: late-onset neurodegeneration is an auto-inflammatory disease.
01
Jan
Drosophila model for mucopolysaccharidosis type III
Honours project: Use the unique capabilities of Drosophila to model and genetically dissect pathogenic pathways that lead from mutation to clinical symptoms in mucopolysaccharidosis type III.
-
Microbiology and immunology projects
Discovery of new genes that promote T cell activity against cancer
Honours project: Help identify novel genes involved in T cell trafficking to solid tumours.
Read more about Discovery of new genes that promote T cell activity against cancerControlling inflammation during influenza infection
Honours project: Investigate Tr1 cell mediated control of tissue damage during influenza infection.
Read more about Controlling inflammation during influenza infectionUnderstanding T cells in autoimmune disease
Honours project: Investigate transcriptional control of inflammatory T helper cells in autoimmunity.
Read more about Understanding T cells in autoimmune diseaseDeep learning for better cellular imaging
Honours project: Help improve the imaging capabilities of scientists studying infection and reproductive biology.
Read more about Deep learning for better cellular imagingStress response in pathogenic bacteria: Haemophilus influenzae
Honours project: Participate in important research into the stress response in pathogenic bacteria, in particular, Haemophilus influenzae which can lead to several serious diseases in humans.
Read more about Haemophilus influenzaeGroup B Strep & oxidative stress
Honours project: Identify the response of Group B Streptococcus to relevant reactive oxygen and reactive nitrogen species.
Read more about Group B Strep & oxidative stressStaphylococcus aureus & lifestyle variations
Honours project: Conduct biomedical research into Staphylococcus aureus (Golden staph).
Read more about Staphylococcus aureus & lifestyle variationsRole of the Actin-Related Protein Complex 1B (ARPC1B) in neutrophil antimicrobial function
Honours project: Investigate the role of the Actin-Related Protein Complex 1B (ARPC1B) in neutrophil antimicrobial function.
Read more about Role of the Actin-Related Protein Complex 1B (ARPC1B) in neutrophil antimicrobial functionBlinatumomab in relapsed acute lymphoblastic leukaemia
Honours project: Investigate resistance mechanisms to the bispecific T-cell engager (BiTE) blinatumomab in relapsed acute lymphoblastic leukaemia.
Read more about Blinatumomab in relapsed acute lymphoblastic leukaemiaComplement receptor immunoglobulin - infection & immunity & inflammation
Honours project: Examine the complement receptor immunoglobulin expression in human macrophages and its role in infection and immunity and inflammation.
Read more about Complement receptor immunoglobulin - infection & immunity & inflammationCloning acute lymphoblastic leukaemia fusion genes and variants
Honours project: Clone full-length fusion-genes and gene variants from patient material into mammalian expression plasmids.
Read more about Cloning acute lymphoblastic leukaemia fusion genes and variantsEfficacy of a combination of TKI and a novel allosteric inhibitor asciminib in chronic myeloid leukaemia
Honours project: Investigate the synergistic effect of the combination of TKI and asciminib.
Read more about Efficacy of a combination of TKI and a novel allosteric inhibitor asciminib in chronic myeloid leukaemiaMonitoring of minimal residual disease on chronic myeloid leukaemia patients in a setting of treatment free remission
Honours project: Characterise the residual leukaemia population in TFR patients, and understand why some patients relapse and others don’t.
Read more about Monitoring of minimal residual disease on chronic myeloid leukaemia patients in a setting of treatment free remissionMetabolic dependencies for improved therapeutic outcomes in chronic myeloid leukaemia
Honours project: Participate in a novel and innovative approach will likely provide a combinational treatment strategy with greater efficacy than current approaches.
Read more about Metabolic dependencies for improved therapeutic outcomes in chronic myeloid leukaemiaJAZ2 is important for Treg function
Honours project: Study novel targets for autoimmune therapy via the validation of Foxp3 regulated genes critical for treg function.
Read more about JAZ2 is important for Treg function
more...01
Jan
CRISPR genome wide screens & viral replication
Honours project: Use CRISPR/Cas9 genome wide screens to identify viral host dependency factors and novel innate immune genes that control viral replication.
01
Jan
Molecular tagging of the dengue virus genome
Honours project: Contribute to the development of effective antivirals that target Dengue virus.
01
Jan
Honours project: This exciting research project will investigate virus purification, the effect of gamma-irradiation on virus structure, and the ability of gamma-irradiated viruses to induce cytotoxic T cell responses.
01
Jan
Drug resistance of malaria parasites
Honours project: Characterise drug sensitivities and resistance mechanisms of different malaria parasite species.
01
Jan
Zika virus infection of the placenta
Honours project: Examine the role of the innate immune response to zika virus infection in the female reproductive tract (FRT) and placenta.
01
Jan
Identifying new drugs that kill parasites
Honours project: Work with a team of researchers who are identifying and characterising novel drugs that kill apicomplexan parasites.
01
Jan
Mixed colony biofilms & disease outcome
Honours project: This molecular and biomedical science honours project explores mixed colony biofilms and their relationship to disease outcomes.
01
Jan
Unwrapping the 3D genome to map autoimmune disease
Honours project: Help unravel the chromatin interactome to map the genetic risk of type 1 diabetes.
01
Jan
Uncovering the relationship between two malaria proteins required for invasion
Honours project: Delve into an honours project in the structural and functional analysis of malaria proteins required for Red Blood Cell invasion.
01
Jan
How the body clears a medically important fungal pathogen
Honours project: This immunopathology research project studies innate immunity in the killing of the fungal pathogen, Candida albicans by human phagocytes.
-
Related projects
Genes controlling seed development
Honours project: Participate in a plant breeding project on dissecting the MADS-box interactome during barley ovule and seed development.
Read more about Genes controlling seed developmentRhizopus arrhizus: Fantastic fungi and how to control them
Honours project: Rhizopus arrhizus is a fast-growing fungus that spoils our food - it also has a huge biotechnological potential.
Read more about Fantastic fungi and how to control themTranscription factors controlling seed development
Honours project: Participate in a plant breeding project understanding seed development in flowering plants.
Read more about Transcription factors controlling seed developmentInvestigating the role of perineuronal nets as a non-cellular mechanism of emotion and mood
Honours project: Investigate perineuronal nets as a non-cellular mechanism of emotion and mood.
Read more about Investigating the role of perineuronal nets as a non-cellular mechanism of emotion and moodCan the novel IVOS biosensor diagnose mastitis in dairy cows?
Honours project: Validate a novel biosensor as a potential diagnostic tool for the diagnosis of subclinical mastitis in dairy cows.
Read more about Can the novel IVOS biosensor diagnose mastitis in dairy cows?Grape berry responses to extreme heat
Honours project: Discover how the biochemistry and physiology of grape berries respond to extremely high temperatures.
Read more about Grape berry responses to extreme heatWhere does the acid in wine come from?
Honours project: Can you help find the missing link in grape berry biochemistry?
Read more about Where does the acid in wine come from?Does eating cruciferous vegetables protect us against breast cancer?
Honours project: Explore the anti-breast cancer actions of isothiocyanates from cruciferous vegetables.
Read more about Does eating cruciferous vegetables protect us against breast cancer?Fossils under a new light
Honours projects: Use new fluorescence imaging techniques to analyse fossils that range in age from half-a-billion to some tens of thousands of years old.
Read more about Fossils under a new lightSaving megafauna from bacteria
Honours projects: Identify and image biofilms that threaten the Naracoorte Caves National Park fossils.
Read more about Saving megafauna from bacteriaIn vitro maturation of canine oocytes
Honours project: Determine the effects of different in vitro maturation (IVM) conditions on the developmental competence of canine oocytes.
Read more about In vitro maturation of canine oocytesAgave spirits: Using wild yeasts to ferment fructose
Honours project: Fermentation of wild yeasts to create Australia's first agave spirit.
Read more about Using wild yeasts to ferment fructoseKoala health and disease in South Australia
Honours project: Join the Koala Health Research Group and contribute to key research to improve the health of current and future animal populations.
Read more about Koala health and disease in South AustraliaWater restriction practices in broiler breeder hens: effect on egg albumen composition
Honours project: Determine the effects of maternal water restriction on egg development by investigating key proteins in the albumen of fertile chicken eggs which are vital for the survival and growth of the chicken embryo.
Read more about effect on egg albumen compositionA sweet treat? Salmonella in raw egg based desserts
Honours project: Combine your interest in food science, animal science and biomedical science by investigating the the behaviour of Salmonella in mousse, tiramisu, and custard.
Read more about A sweet treat? Salmonella in raw egg based dessertsGenetic mutations associated with skin & wool growth in sheep
Honours project: Identify genetic mutations in sheep DSC1 & DSG4 genes essential for skin and wool follicle architecture.
Read more about Genetic mutations associated with skin & wool growth in sheepOccurrence & distribution of ticks in South Australia
Honours project: Outbreaks of the tick-transmitted parasitic disease Theileriosis in South Australia has raised questions regarding the presence of the tick vector.
Read more about Occurrence & distribution of ticks in South AustraliaPathogenesis of newly emerged Newcastle disease virus in South East Asia
Honours project: Investigate molecular basis of pathogenicity of the Newcastle disease virus and provide preliminary information to develop new vaccines for protection of poultry in Indonesia.
Read more about Pathogenesis of newly emerged Newcastle disease virus in South East AsiaEvaluation of monoclonal antibodies in detection of avian influenza antigens
Honours project: Evaluate different recombinant and non-recombinant monoclonal antibodies against M2e antigen of avian influenza virus, to find the most reactive antigens and antibodies
Read more about Evaluation of monoclonal antibodies in detection of avian influenza antigensAssessing cellular response to bioactive compounds as a prelude to testing in vivo
Honours project: Establish tissue culture and tissue explant systems for the bovine mammary gland.
Read more about Assessing cellular response to bioactive compounds as a prelude to testing in vivoGrowth signalling pathways acting on the intestinal stem cell
Honours project: This project aims to access activity of positive and negative signalling pathways that act on intestinal stem cells in pigs.
Read more about Growth signalling pathways acting on the intestinal stem cell4D in vivo biophotonics for metabolism and pain in real time
Honours project: Participate in an emerging area of science which could improve outcomes for type-1 diabetes sufferers as well as provide crucial redox balance information for athletes, livestock and plants.
Read more about 4D in vivo biophotonics for metabolism and pain in real timeViable, but non-culturable bacteria: Understanding the risks for food safety
Honours project: This project aims to determine the ability of viable but non culturable bacteria to cause disease.
Read more about Understanding the risks for food safetyIsolation & evaluation of protein pattern of koala retroviruses
Honours project: Determine the antigenic pattern of isolated Koala retroviruses in South Australia.
Read more about Isolation & evaluation of protein pattern of koala retrovirusesFull genome sequencing of recombinant strains of canine hepatitis
Honours project: Full genome sequencing will be performed to find the genomic structure of a new infectious canine hepatitis virus.
Read more about Full genome sequencing of recombinant strains of canine hepatitisExploring the interactions between Salmonella and Campylobacter species
Honours project: Characterise both intra- and intercellular interactions between Salmonella and Campylobacter.
Read more about Exploring the interactions between Salmonella and Campylobacter speciesWater quality - disinfecting water with chlorine
Honours project: How does tap water with added chlorine impact our stomach?
Read more about Water quality - disinfecting water with chlorineHistopathology in Pacific oyster health surveillance
Honours project: Look for health and signs of disease in Coffin Bay oysters, and develop the procedures for a statewide oyster health surveillance program.
Read more about Histopathology in Pacific oyster health surveillanceHeavy metal resistance in E. coli isolated from pigs
Honours project: Explore resistance to heavy metals in an Australia-wide collection of multidrug-resistant Escherichia coli (E. coli) isolated from pigs.
Read more about Heavy metal resistance in E. coli isolated from pigsHeavy metal resistance in carbapenem-resistant bacteria
Honours project: Mechanisms of heavy metal resistance in carbapenem-resistant Enterobacteriaceae isolated from humans, animals and the environment.
Read more about Heavy metal resistance in carbapenem-resistant bacteria
more...01
Sep
Using the ancient DNA to explore human adaptation & evolutionary medicine
Honours project: Get involved in research into human adaptation and evolutionary medicine.
01
Jan
New Metal-organic frameworks for Biomacromolecule Protection
Honours project: Investigate new metal-organic frameworks for biomacromolecule encapsulation and protection

![Salmonella species growing on X.L.D. agar Nathan Reading [CC BY-NC-ND 2.0]](/sites/default/files/styles/ua_landscape/public/media/images/2019-05/salmonella.jpg?h=0d6ba564&itok=7Hdw3dw7)


![Campylobacter - CDC [Public domain]](/sites/default/files/styles/ua_landscape/public/media/images/2019-05/campylobacter.jpg?h=44be63ab&itok=DZHPCSbz)



